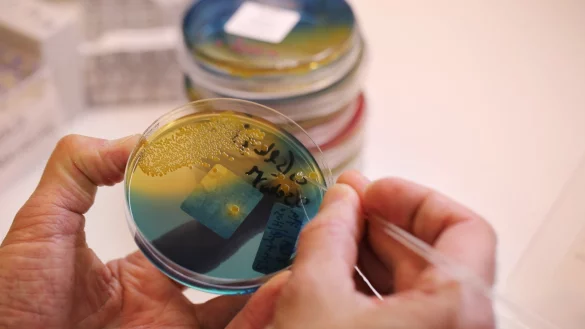
Gewebeproben - &copy; Foto: &Oslash;rn E. Borgen/NTB scanpix

Oslo - Es war früh am Freitagmorgen, als Tiril Aasheim im norwegischen Kløfta merkte, dass etwas mit ihrer Hündin Bolla nicht stimmte. Der sonst so quirlige Zwergspitz war schlapp und hatte in der Nacht Durchfall gehabt.
«Sie wollte nicht rausgehen und als ich sie hochhob, erbrach sie sich und das Blut rannte förmlich aus ihrem Hintern», erzählt Aasheim. Über Nacht war das zweieinhalb Jahre alte Tier so krank geworden, dass sein Leben auf der Kippe stand.
So geht es zurzeit in Norwegen geschätzt mehr als 100 Hunden. Ganz plötzlich geht es ihnen schlecht, sie müssen sich erbrechen und bekommen blutigen Durchfall. Mehr als 25 Hunde sind nach Angaben von Dienstag schon an den Folgen dieser mysteriösen Krankheit gestorben.
So lange unklar ist, warum die Hunde krank werden, sind ihre Besitzer aufgefordert zu vermeiden, dass ihr Vierbeiner mit anderen Hunden in Kontakt kommt. Zahlreiche Veranstaltungen mit Hunden wurden abgesagt. Die beliebten öffentlichen Hundeplätze in Oslo, wo die Tiere frei herumlaufen können, sind verwaist. Wer sein Tier Gassi führt, hält es an der kurzen Leine. Viele Halter haben Angst.
Für die Veterinäre ist die Infektion ein Rätsel. Sie wissen nicht, wodurch sie ausgelöst wird und ob sie ansteckend ist. Nur, dass es ganz schnell geht. Innerhalb von 24 Stunden kann ein gesundes Tier plötzlich tot sein. Doch nicht alle sterben daran. Die meisten, so versichert Asle Haukaas vom Veterinärinstitut in Oslo, könnten bei rechtzeitiger Behandlung wieder auf den Damm kommen.
So auch Bolla. Ihr Frauchen brachte sie noch am selben Tag in die Tierklinik, wo man schon eine abgetrennte Abteilung für die Hunde mit diesen Symptomen eingerichtet hatte. Sie bekam sechs verschiedene Medikamente und musste über Nacht isoliert im Keller bleiben. Doch am nächsten Tag konnte Bolla wieder mit nach Hause. «Der Arzt sagte, wären wir nur ein paar Stunden später gekommen, wäre sie tot gewesen», berichtet die ältere Dame. Nun hat sie Angst, dass ihr zweiter Hund, der wesentlich gebrechlicher ist, auch die mysteriöse Krankheit bekommen könnte.
Das Veterinärinstitut und die Lebensmittelaufsicht in Norwegen arbeiten nun mit Hochdruck daran, dem Erreger der Krankheit auf die Spur zu kommen. Das könnten Bakterien, Viren, Pilze, Parasiten und Algen sein - oder die Folgen von Regen, Temperatur oder schlechter Wasserqualität. Auch frühere Fälle im In- und Ausland würden untersucht. Erste Obduktionen weisen darauf hin, dass alle Hunde eine kräftige, blutige Darmentzündung hatten. Zwei Bakterien wurden bislang nachgewiesen: Providencia alcalifaciens und Clostridium perfringens.
«Bakterienerkrankungen spielen bei Hunden normalerweise nicht so die große Rolle», meint die deutsche Tierärztin Johanna Rieder von der Tierärztlichen Hochschule in Hannover. Zwar seien Durchfallerkrankungen bei diesen Tieren relativ häufig. Doch dass so viele Hunde in einer Region so schnell stürben, sei nicht normal. So lange sie die Ursache nicht kenne, könne sie deutschen Hundebesitzern aber keinen konkreten Rat geben, außer vorsichtig zu sein, wenn sie nach Norwegen reisen sollten.
Da es in dem skandinavischen Land kein zentrales Gesundheitsregister für Erkrankungen bei Hunden gibt, hat das Veterinärinstitut nun ein Schema an alle Tierärzte und -kliniken geschickt. Die Mediziner sind aufgefordert, alle Fälle von blutiger Diarrhö, Erbrechen und schlechtem Allgemeinzustand bei Hunden seit dem 1. August zu melden. «Die Formulare enthalten hoffentlich viele wertvolle Informationen, die helfen, die Ursache der Krankheit zu ermitteln», heißt es auf der Webseite des Veterinärinstituts. In Norwegen gibt es dem Norsk Kennel Klub zufolge rund 560.000 Hunde.
Sicher ist bislang nur, dass die Tiere nicht vergiftet wurden. Auch eine Infektion mit Salmonellen oder Campylobacter kann ausgeschlossen werden.
Tiril Aasheim lässt ihre Hunde nun nicht mehr aus den Augen. «Ich trage sie jetzt an den Waldrand, wo keine anderen Hunde sind», sagt sie. Sie will möglichst vermeiden, auf andere Hundebesitzer zu stoßen. «Ich habe das Gefühl, dass mich jetzt alle komisch angucken.»